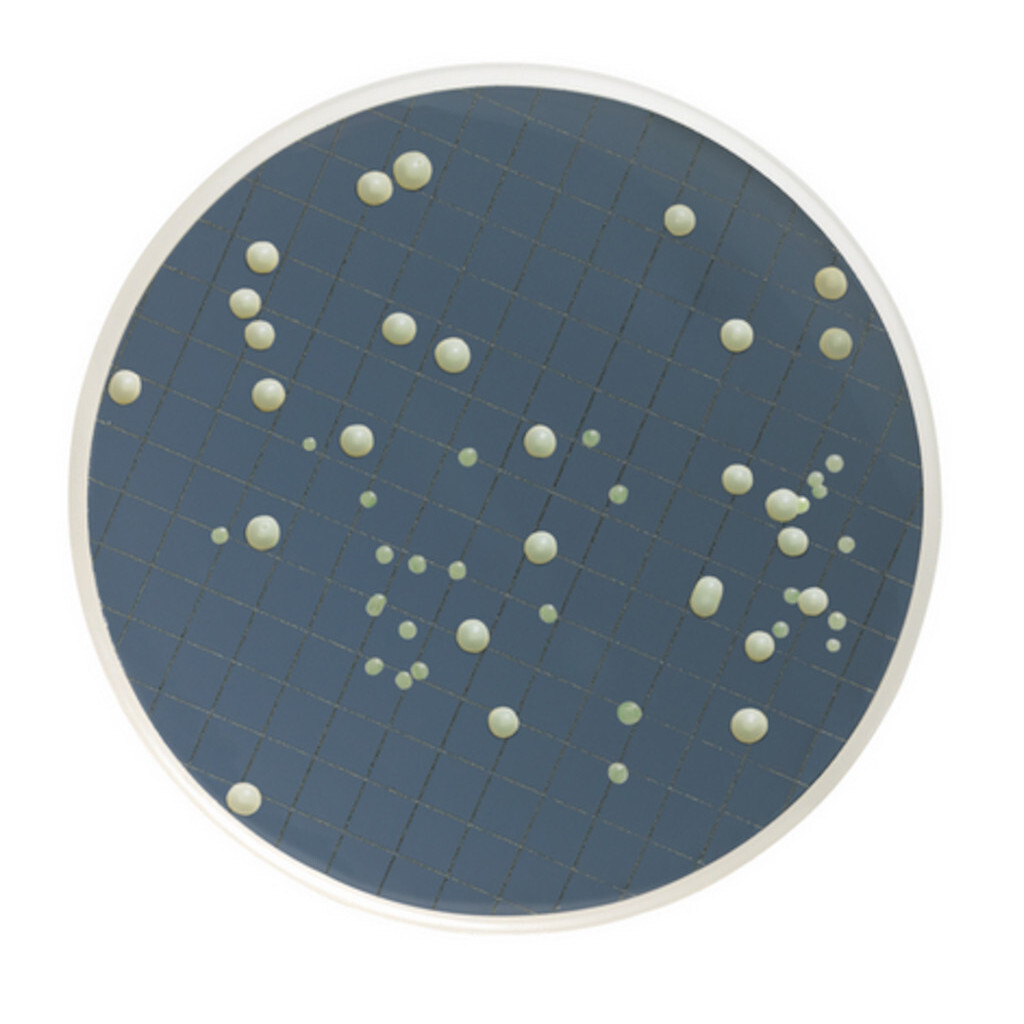
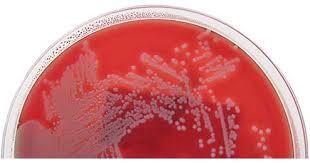
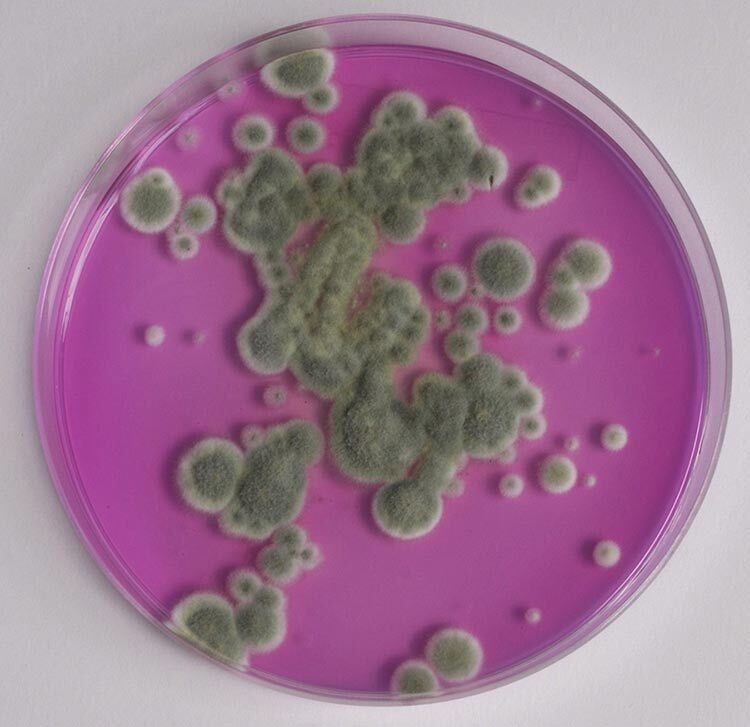
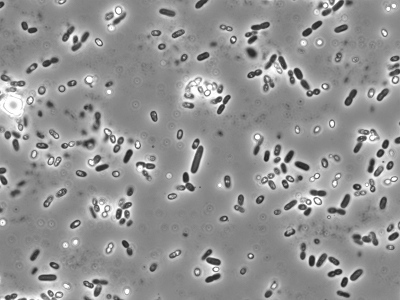

macroscopique ?
levure + cremeuse
macroscopique?
Bactéries : Les colonies bactériennes sont souvent plus petites, opaques ou translucides, avec une texture lisse et brillante (ex. E. coli). Certaines bactéries peuvent aussi former un biofilm visqueux.
macroscopique?
moisissure
micro

levure
micro
bact
micro

moisi
coloration selon le micro organisme
b : coloration simple cristal violet
m : bleu de coton
l : coloration iode
Coloration simple étapes pratiqué en vrai
FROTTIS A FAIRE AVANT
la pince métallique, utilisée pour flamber la lame, ne doit PAS être utilisée lors de la coloration.
Les colorants peuvent être légèrement irritants. Porter des lunettes de protection.
1.Les micro-organismes sur la lame doivent préalablement avoir été fixés et la lame doit être refroidie (voir la procédure pour effectuer un frottis).
2.Déposer la lame sur les tiges horizontales au-dessus de l’évier.
3.Il s’agit tout simplement de mettre le colorant désiré (au choix : cristal violet, bleu de coton, safranine, etc.) sur la lame et d’attendre 60 secondes.
4.Rincer à l’eau distillée les deux côtés de la lame, sans que le jet d’eau ne soit directement dirigé sur le frottis.
5.Enlever le surplus de liquide et mettre la lame dans le papier buvard pour l’assécher. Tapoter doucement pour éviter de casser la lame.
6.Observer au microscope.
coloration bleu de coton étape
Le bleu de coton est légèrement irritant. Porter des lunettes de protection.
1.Laver la lame avec le nettoyant à vitre.
2.Déposer une goutte du colorant Bleu de coton sur la lame, puis l’étaler en partant d’un côté et en créant une ligne sur la longueur de la lame.
3.Couper un bout de ruban gommé un peu plus court que la lame.
4.Faire une boucle avec le ruban, côté gommé vers l’extérieur, en faisant attention de ne pas toucher le centre du morceau de ruban avec les doigts.
5.Appuyer légèrement le ruban (côté gommé) sur le dessus de la culture de moisissures. 6.Prélever des hyphes végétatifs (sur le pourtour de la colonie) et des hyphes reproducteurs (avec spores, qui sont habituellement colorées).
7.Coller votre ruban gommé sur la lame, en vous assurant que l’étalement du colorant est uniforme. Ne pas appuyer sur le ruban, pour éviter de briser les structures.
8.Observer ensuite les moisissures à Gt de 100X ou 400X.
coloration iode étapes
1.Laver la lame avec le nettoyant à vitre.
2.Déposer une goutte de solution d’iode diluée sur la lame.
3.Prélever, avec l’aiguille préalablement stérilisée, quelques cellules de levures en touchant une colonie isolée.
4.Étaler dans la solution d’iode.
5.Déposer délicatement une lamelle et utiliser un papier absorbant pour enlever le surplus d’iode, si nécessaire.
Observer à Gt de 400X.
effectuer un frottis PETRI étape
—Étapes préalables communes à tous les types de frottis
1.Nettoyer la lame avec le nettoyant à vitre en lavant les deux côtés simultanément.
2.Placer la lame dans la pince métallique, verser de l’alcool-acétone sur la lame, égoutter un peu et flamber avec la flamme-pilote pour dégraisser la lame et permettre la fixation des bactéries qui suivra.
3.Faire un carré avec le crayon à pointe de diamant et identifier votre lame.
—Pour les bactéries en plat de Pétri
4.À l’aide d’un compte-goutte, déposer une goutte d’eau distillée au centre du carré tracé sur la lame préparée.
5.Toucher, à l’aide de l’aiguille ou de la boucle stérilisée, la colonie sélectionnée. Il ne faut pas trop prendre de bactéries.
6.Sur la lame, étaler la matière solide présente sur l’instrument dans la goutte d’eau distillée de façon à couvrir le carré dessiné sur votre lame (cela peut même déborder du carré).
7.Stériliser l’instrument. Attention de ne pas produire d’aérosols !
8.Laisser sécher le frottis complètement à l’air. Cela peut se faire près de la flamme, afin d’accélérer le processus de séchage.
9.Fixer votre frottis par un mouvement de trois passages rapides au-dessus de la flamme. Ces passages auront pour effet de faire adhérer vos organismes sur votre lame pour qu’ils ne puissent pas être lavés lors des étapes de coloration.
Tester la chaleur de votre lame sur le dos de votre main. La chaleur doit être tolérable sans être brûlante. Si vous avez trop chauffé, vous risquez d’avoir carbonisé la matière organique.
Laisser refroidir votre lame avant de procéder aux autres étapes, pour éviter la cristallisation des colorants.
effectuer frottis BOUILLON étapes
Réaliser une figure complète lors d’un dessin au microscope.

Effectuer une identification complète de ses milieux de culture.
TBE - GPG - VEND - 9h00 - 13/09/25 - E.coli - milieu SAB - 25C
(techniques d’ensemencement, culot et gelose



